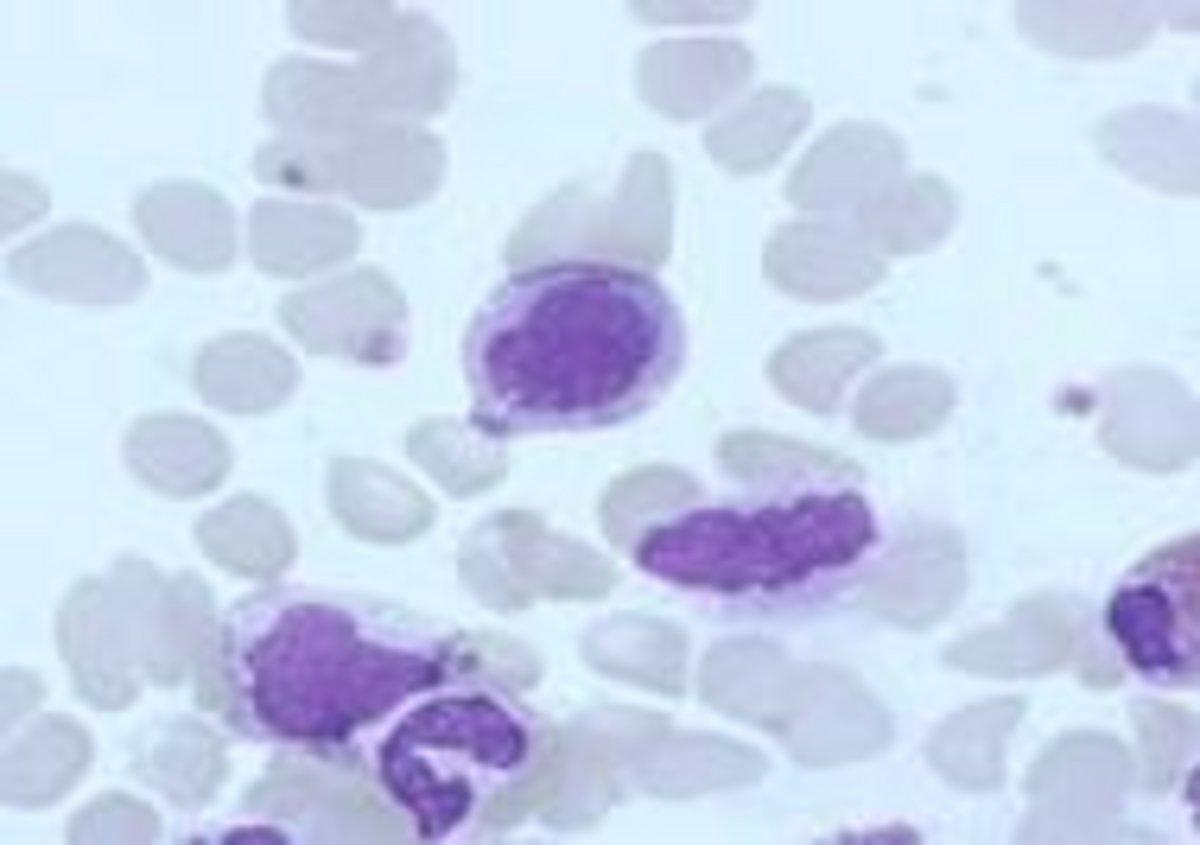
Field from RBC section showing numerous monocytes

Quality Slide Program (QSP) 2.0
Available as a single use license and a site license which allows up to 50 concurrent users.
March 2023
Monthly Digital Case Study
March 2023 QSP Slides
Malaria
Quiz
(PDF for print)
March 2023 QSP Slide 1:
Platelet clumps
Field from RBC section showing numerous monocytes
FBC Results | |||
| WBC | 20.7* (10^3/mm3) | Neutrophils | 74.0% |
| RBC | 3.59 (10^6/mm3) | Lymphocytes | 9.4% |
| HGB | 9.8 (g/dL) | Monocytes | 15.0% |
| HCT | 29.4 (%) | Eosinophils | 1.6% |
| MCV | 82 (fL) | Basophils | 0.0% |
| MCH | 27.3 (pg) | Myelocytes | 0.0% |
| MCHC | 33.3 (g/dL) | Large Platelets | Present |
| PLT | 432* (10^3/mm3) | ||
Clinical Details: Female (90 years old)
Slide Information: Polyvalent Post-Emergency Internal Medicine unit. Monocytosis. Platelet aggregates and macroplatelets (++).
On the occasion of World Malaria Day in April, this month's issue will once again feature previously delivered content on malaria.
Malaria is a worldwide disease that it is transmitted to humans via the Anopheles Mosquito, through a bite. Malaria is found in tropical and subtropical regions of the world.
The mosquito bite introduces the parasite into the human’s blood via sporozoites in the saliva. The parasites then migrate to the liver, where they mature and reproduce. This is known as the exoerythrocytic phase.
The organisms multiply in the liver in infected hepatocytes. These differentiate into thousands of merozoites, which rupture the host cell, infiltrating the blood and infecting red blood cells. This next stage is known as the erythrocytic stage of the life cycle. The parasite is able to leave the liver undetected as it envelopes itself in the cell membrane of the infected host liver cell.
There are four commonly known types of malaria parasite, Plasmodium falciparum, Plasmodium Vivax, Plasmodium Ovale, and Plasmodium Malariae. The most severe is Plasmodium falciparum, the lesser common is Plasmodium Knowlesi.
Each has variations which help identification (see table below):
Observation | P. Falciparum | P. Vivax | P. Malariae | P. Ovale |
|---|---|---|---|---|
| Size (RBC) | Not enlarged | Enlarged | Not enlarged | Enlarged |
| Shape (RBC) | Round, sometimes crenated | Round or oval | Round | Round or oval, often fimbriated |
| Colour (RBC) | Normal, but may become darker or may have a purple rim | Normal to pale | Normal | Normal |
| Stippling (RBC) | Maurer’s spots, appear as large red spots, loops and clefts | Schuffner’s dots, appear as small red dots, numerous | Ziemann’s dots, few tiny dots, rarely detected | Schuffner’s dots (James’s dots). Numerous small red dots |
| Pigment (RBC) | Black or dark brown | Seen as a haze of fine golden brown granules scattered through the cytoplasm | Black or brown coarse granules, scattered | Intermediate between P. Vivax and P. Malariae |
| Trophozoite (parasite) | Small, delicate, sometimes two chromatin dots, multiple rings commonly found | Relatively large, one chromatin dot, sometimes two, often two rings in one cell | Compact, one chromatin dot, single | Compact, one chromatin dot, single |
| Schizont (parasite) | Medium size | Large | Small | Medium |
| Gametocyte (parasite) | Crescent shaped | Spherical | Similar to P. Vivax, but smaller and less frequent | Like P. Vivax but smaller |
P. Falciparum - trophozoites and crescent shaped gametocyte
P. Vivax - Gametocyte (L) and trophozoite (R)
Testing for the diagnosis of malaria is confirmed by a microscopic (blood films) and no-microscopic (FBC, rapid test) tests. See next newsletter.
Bibliography
Essential Haematology, A.V .Hoffbrand & J.E.Pettit https://www.ncbi.nlm.nih.gov/books/NBK555962/
Do you have any questions or requests? Use this form to contact our specialists.